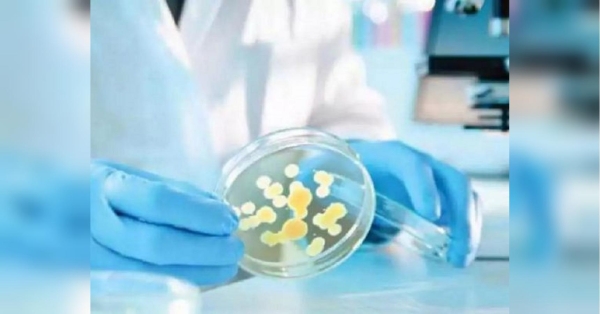
Понад 100 курсантів морського ліцею в Одесі звернулися до лікарні через отруєння, — ЗМІ - INFBusiness

Автоексперти розповіли, чому водії Subaru, BMW та Porsche порушують правила частіше за інших

Після того, як експерти назвали два популярні німецькі автомобілі, які краще не купувати, автоексперти з Британії визначили автомобілі, власники яких найчастіше